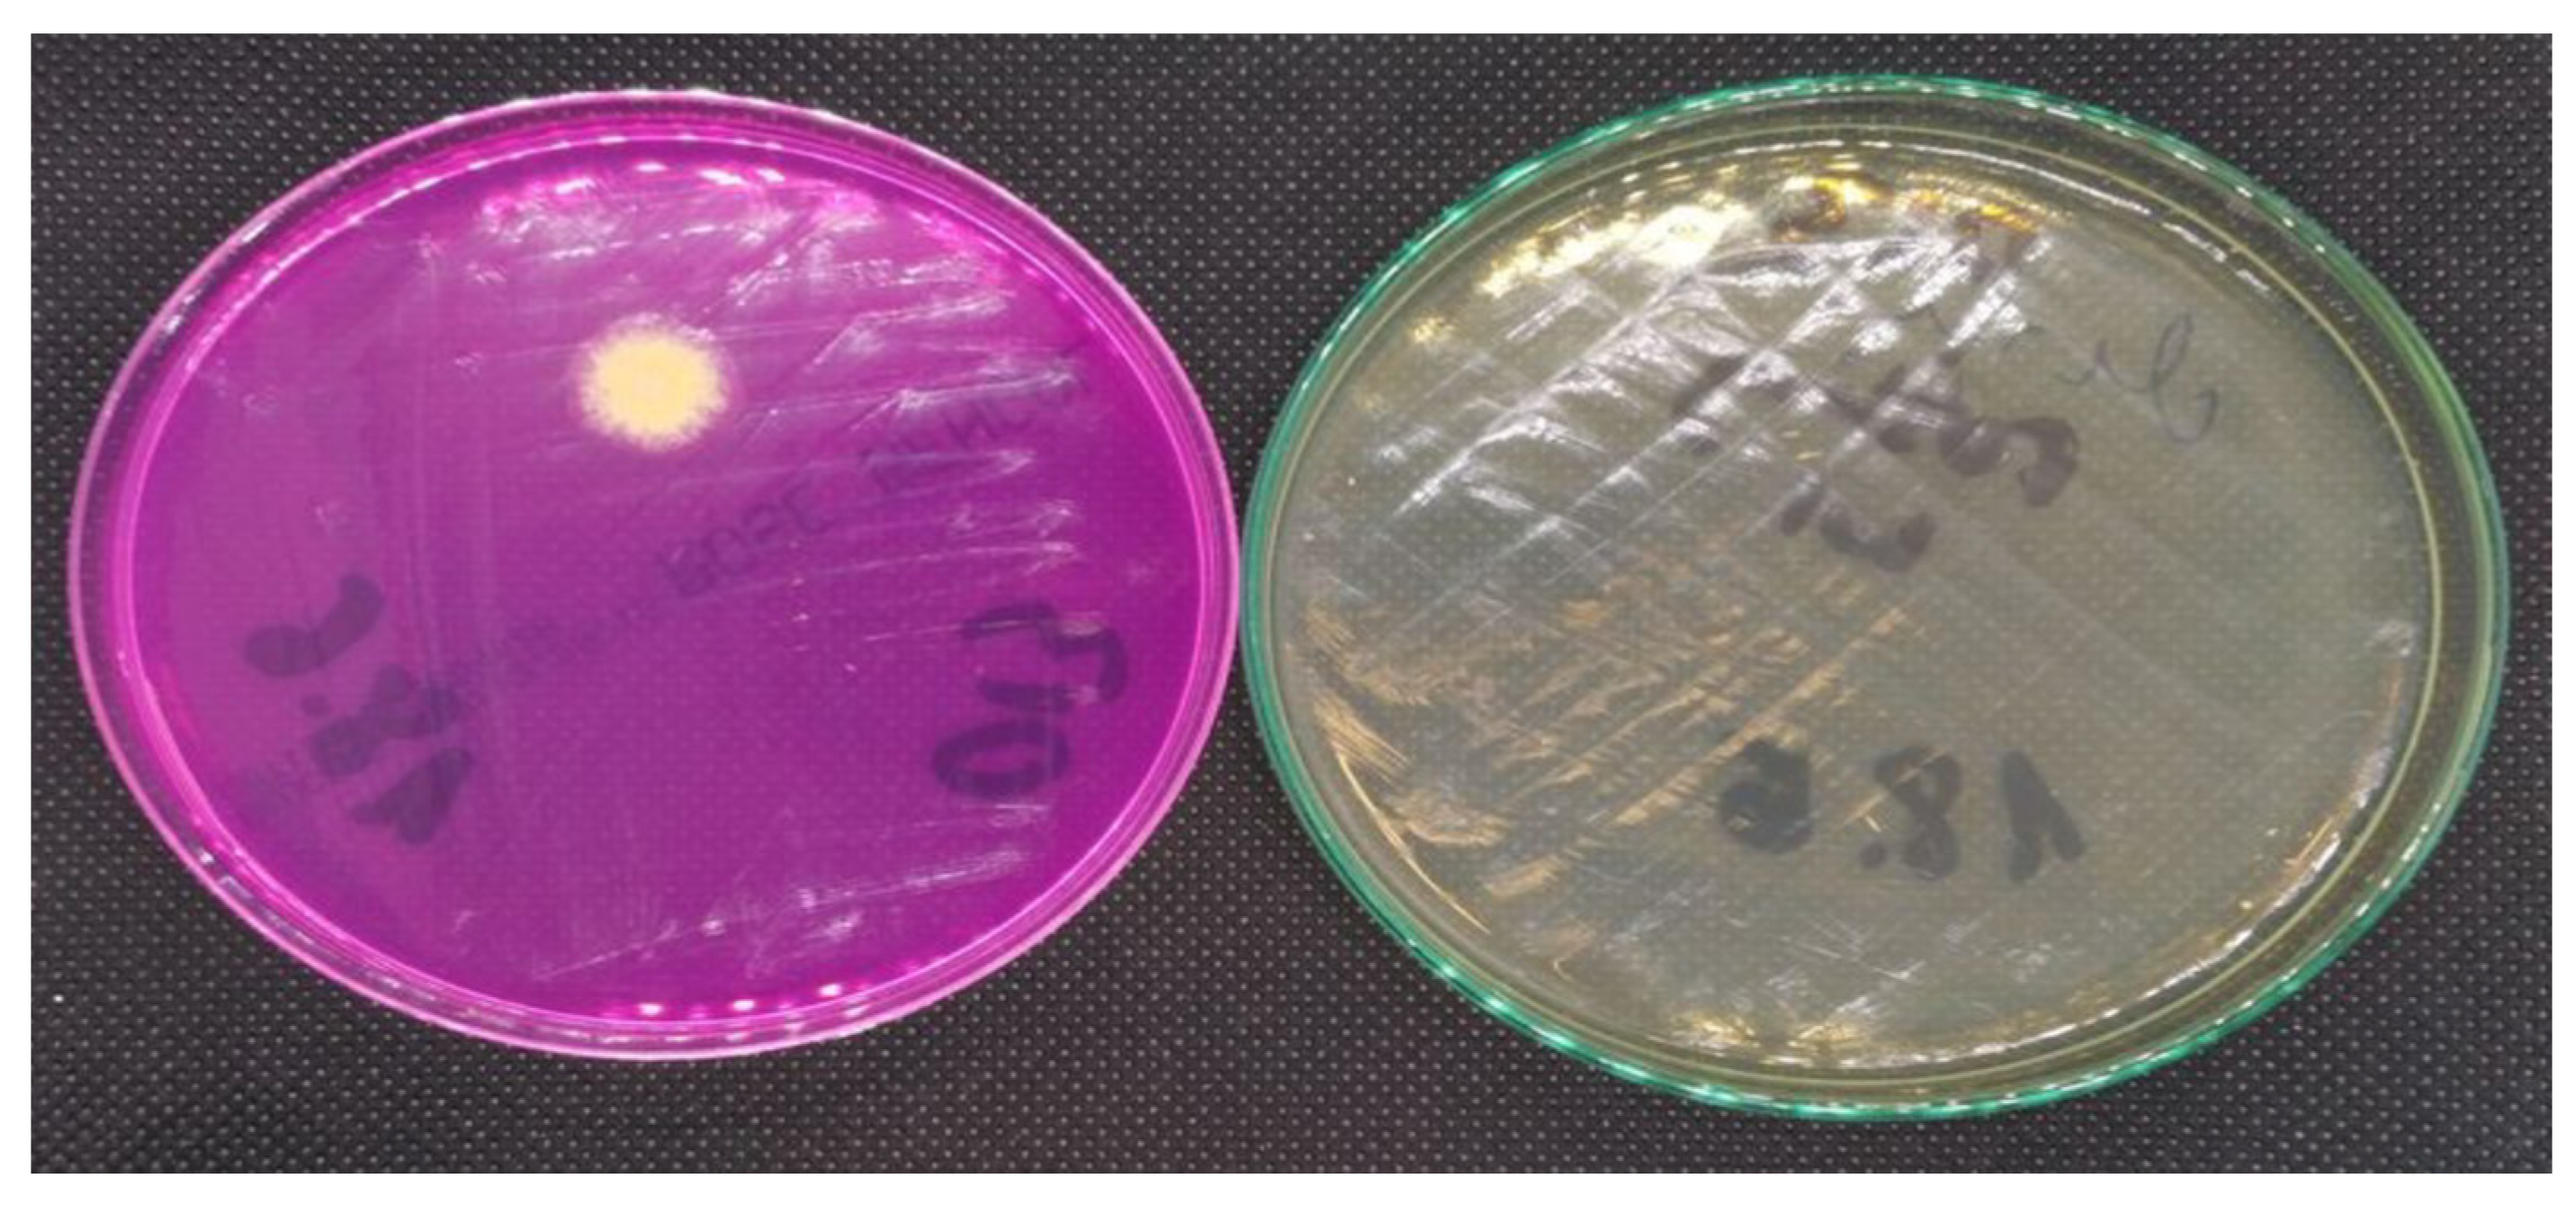
Energies 13 06051 g009 Energies 13 06051 g009

Implementation of the Indoor Environmental Quality (IEQ) Model for the Assessment of a Retrofitted Historical Masonry Building
Abstract
1. Introduction
2. Materials and Methods
2.1. Scope of Experimental Work
- Definition of boundary conditions for a method including case study definition with measurement strategy, equipment selection, determination of uncertainty.
- Measurements of indoor quality elements including air pollution; CO2, volatile organic compounds (VOCs), fungal contamination, thermal comfort parameters, acoustic measurements, and intensity of light.
- Conversion of measured physical values to predicted user satisfaction levels based on specific sensory equations/models.
- Providing a new equation of user satisfaction level based on fungal air concentration and reference values from the literature.
- Calculation of the IEQindex (measurement-based) value for the assessed building space before and after retrofitting (based on calculated sub-component values).
- Calculation of the IEQindex (users questionnaire-based) value for the assessed building space before and after retrofitting (based on sub-component values).
- In-depth mycological analysis of the object.
- Assessment of the influence of applied thermal insulation system on the comfort parameters and environmental quality.
- Comparison of IEQindex results by vote (questionnaire) and measurement method.
- Discussion of the results.
2.2. Case-Study Building and Retrofitting Method
2.3. Indoor Environmental Quality Model and Sub-Elements
2.4. Equipment and Experimental Tests Methodology
2.4.1. Thermal Comfort Measurement
2.4.2. Indoor Air Quality Tests (CO2, TVOC, HCHO, and CFU)
2.4.3. Sound Level Tests
2.4.4. Visual Comfort Test
2.4.5. Subjective Indoor Comfort test by Questionnaire—Vote Assessment
2.4.6. Limitations and Assumptions of the Adopted Method
3. Results
3.1. Overall IEQ Index (Measurement Method) and Values of Comfort Sub-Component Indexes
3.2. Microbiological Results
3.3. Air Quality Test Results Concerning the Presence of VOSs and Relative Indoor Humidity of External Walls
3.4. Thermal Comfort Testing Results
3.5. Results Concerning the Comfort of Use by Questionnaire (Vote) Method
4. Discussion of Results and Conclusions
Author Contributions
Funding
Acknowledgments
Conflicts of Interest
Appendix A. Outdoor Weather Data for the Measuring Periods


References
- Act of 7 July 1994, Building Law. J. Laws 1994. Available online: https://isap.sejm.gov.pl/isap.nsf/download.xsp/WDU19940890414/U/D19940414Lj.pdf (accessed on 1 November 2020). (In Polish)
- Act of 23 July 2003, The Protection of Monuments and the Care of Monuments. J. Laws 2003. Available online: http://isap.sejm.gov.pl/isap.nsf/download.xsp/WDU20031621568/T/D20031568L.pdf (accessed on 1 November 2020). (In Polish)
- Obwieszczenie Ministra Infrastruktury i Rozwoju z dnia 17 lipca 2015 r. w Sprawie Ogłoszenia Jednolitego Tekstu Rozporządzenia Ministra Infrastruktury w Sprawie Warunków Technicznych, Jakim Powinny Odpowiadać Budynki i ich Usytuowanie (Dz. U. No 75, pos. 690), as Amended. Available online: http://prawo.sejm.gov.pl/isap.nsf/DocDetails.xsp?id=WDU20150001422 (accessed on 19 December 2019). (In Polish)
- Bak, J.; Radziszewska–Zielina, E.; Zielina, M. Analysis of the spatial structure of green building in the aspect of selected environmental issues on the example of the city of Cracow (Poland). In Proceedings of the IOP Conference Series: Materials Science and Engineering, Prague, Czech Republic, 17–21 June 2019; Volume 603, pp. 1–10. [Google Scholar]
- Radziszewska-Zielina, E.; Kania, E.; Śladowski, G. Problems of the Selection of Construction Technology for Structures of Urban Aglomerations. Arch. Civ. Eng. 2018, 64, 55–71. [Google Scholar] [CrossRef]
- Radziszewska-Zielina, E.; Śladowski, G. Proposal of the Use of a Fuzzy Stochastic Network for the Preliminary Evaluation of the Feasibility of the Process of the Adaptation of a Historical Building to a Particular Form of Use. In Proceedings of the WMCAUS IOP Conference Series: Materials Science and Engineering, Prague, Czech Republic, 12–16 June 2017; Volume 245, p. 072029. [Google Scholar]
- Fedorczak-Cisak, M.; Radziszewska-Zielina, E.; Orlik-Kożdoń, B.; Steidl, T.; Tatara, T. Analysis of the thermal retrofitting potential of the external walls of podhale’s historical timber buildings in the aspect of the non-deterioration of their technical condition. Energies 2020, 13, 4610. [Google Scholar] [CrossRef]
- Radziszewska-Zielina, E.; Rumin, R. Analysis of the Profitability of Investment in Renewable Energy Sources on The Example of a Semi-Detached House. In Proceedings of the International Conference on the Sustainable Energy and Environment Development SEED, Krakow, Poland, 17–19 May 2016; Volume 10, p. 00079. [Google Scholar]
- Fedorczak-Cisak, M.; Kowalska, A.; Radziszewska-Zielina, E.; Śladowski, G.; Pachla, F.; Tatara, T. A multicriteria approach for selecting the utility function of the historical building “Stara Polana” located in Zakopane. In Proceedings of the 64 Scientific Conference of the Committee for Civil Engineering of the Polish Academy of Sciences, Krynica Zdroj, Poland, 16–20 September 2018; Volume 262, p. 07002. [Google Scholar]
- Fedorczak-Cisak, M.; Kowalska-Koczwara, A.; Nering, K.; Pachla, F.; Radziszewska-Zielina, E.; Śladowski Tatara, T.G.; Ziarko, B. Evaluation of the Criteria for Selecting Proposed Variants of Utility Functions in the Adaptation of Historic Regional Architecture. Sustainability 2019, 11, 1094. [Google Scholar] [CrossRef]
- Troi, A.; Bastian, Z. Energy efficiency solutions for historic buildings. In A Handbook; Birkhauser Verlag GmbH: Basel, Switzerland, 2015; ISBN 978-3-03821-646-9. [Google Scholar]
- Loganina, V.; Frolov, M.; Fediuk, R. Developed Heat-insulating Dry Mortar Mixes for the Finishing of Aerated Concrete Walls. Mag. Concr. Res. 2020, 19, 1–14. [Google Scholar] [CrossRef]
- Loganina, V.; Fediuk, R.; Usanova, K.; Timokhin, R. Regularities of Change in the Properties of Paint Coatings on Cement Concretes at Moistening. In Proceedings of the International Scientific Conference on Energy, Environmental and Construction Engineering, Petersburg, Russia, 19–20 November 2019; Volume 70, pp. 1–14. [Google Scholar] [CrossRef]
- Bottino-Leone, D.; Larcher, M.; Herrera-Avellanosa, D.; Haas, F.; Troi, A. Evaluation of natural-based internal insulation systems in historic buildings through a holistic approach. Energy 2019, 181, 521–531. [Google Scholar] [CrossRef]
- Moses, L.; Morrissey, K.; Sharpe, R.A.; Taylor, T. Exposure to Indoor Mouldy Odour Increases the Risk of Asthma in Older Adults Living in Social Housing. Int. J. Environ. Res. Public Health 2019, 16, 2600. [Google Scholar] [CrossRef]
- Maus, R.; Goppelsroder, A.; Umhauer, H. Survival of bacterial and mold spores in airfilter media. Atmos. Environ. 2001, 35, 105–113. [Google Scholar] [CrossRef]
- Hippelein, M.; Rügamer, M. Ergosterol as an indicator of mould growth on building materials. Int. J. Hyg. Environ. Health 2004, 207, 379–385. [Google Scholar] [CrossRef]
- Cox-Ganser, J.M. Indoor dampness and mould health effects—Ongoing questions on microbial exposures and allergic versus nonallergic mechanisms. Clin. Exp. Allergy 2015, 45, 1478–1482. [Google Scholar] [CrossRef]
- Gutarowska, B. Metabolic activity of moulds as a factor of building materials biodegradation. Pol. J. Microbiol. 2010, 59, 119–124. [Google Scholar] [CrossRef]
- Nielsen, K.F.; Gravesen, S.; Nielsen, P.A.; Andersen, B.; Thrane, U.; Frisvad, J.C. Production of mycotoxins on artificially and naturally infested building materials. Mycopathologia 1999, 145, 43–56. [Google Scholar] [CrossRef] [PubMed]
- Pasanen, A.L.; Kasanen, J.P.; Rautiala, S.; Ikaheimo, M.; Kaariainen, H.; Kalliokoski, P. Fungal growth and survival in building materials under fluctuating moisture and temperature conditions. Int. Biodeterior. Biodegrad. 2000, 46, 117–127. [Google Scholar] [CrossRef]
- Kwaśniewska-Sip, P.; Cofta, G.; Nowak, P.B. Resistance of fungal growth on Scots pine treated with caffeine. Int. Biodeterior. Biodegrad. 2018, 132, 178–184. [Google Scholar] [CrossRef]
- Radziszewska-Zielina, E.; Czerski, P.; Grześkowiak, W.; Kwaśniewska-Sip, P. Comfort of Use Assessment in Buildings with Interior Wall Insulation based on Silicate and Lime System in the Context of the Elimination of Mould Growth. Arch. Civ. Eng. 2020, 66, 89–104. [Google Scholar]
- Ncube, M.; Riffat, S. Developing an indoor environment quality tool for assessment of mechanically ventilated office buildings in the UK—A preliminary study. Build. Environ. 2012, 53, 26–33. [Google Scholar] [CrossRef]
- Piasecki, M.; Kostyrko, K.; Pykacz, S. Indoor environmental quality assessment: Part 1: Choice of the indoor environmental quality sub-component models. J. Build. Phys. 2017, 41, 264–289. [Google Scholar] [CrossRef]
- Sarbu, I.; Sebarchievici, C. Aspects of indoor environmental quality assessment in buildings. Energy Build. 2013, 60, 410–419. [Google Scholar] [CrossRef]
- Zuhaib, S.; Manton, R.; Griffin, C.; Hajdukiewicz, M.; Keane, M.M.; Goggins, J. An Indoor Environmental Quality (IEQ) assessment of a partially-retrofitted university building. Build. Environ. 2018, 139, 69–85. [Google Scholar] [CrossRef]
- EN 16798-1:2019. Indoor Environmental Input Parameters for Design and Assessment of Energy Performance of Buildings Addressing Indoor Air Quality, Thermal Environment, Lighting and Acoustics. Available online: https://sklep.pkn.pl/pn-en-16798-1-2019-06e.html (accessed on 1 November 2020).
- ANSI/ASHRAE Standard 55:2017. Thermal Environmental Conditions for Human Occupancy; ANSI: Piscataway, NJ, USA, 2017.
- Enescu, D.; Van Der Linden, W.; Loomans, M.; Hensen, J. CBE Thermal Comfort Tool for EN-16798. Renew. Sustain. Energy Rev. 2017, 79, 1353–1379. [Google Scholar] [CrossRef]
- Nagy, R.; Mečiarová, L.; Vilčeková, S.; Burdová, E.K.; Košičanová, D. Investigation of a ventilation system for energy efficiency and indoor environmental quality in a renovated historical building: A case study. Int. J. Environ. Res. Public Health 2019, 16, 4133. [Google Scholar] [CrossRef]
- Sharif-Askari, H.; Abu-Hijleh, B. Review of museums’ indoor environment conditions studies and guidelines and their impact on the museums’ artifacts and energy consumption. Build. Environ. 2018, 143, 186–195. [Google Scholar] [CrossRef]
- Jaggs, M.; Palmer, J. Energy performance indoor environmental quality retrofit—A European diagnosis and decision making method for building refurbishment. Energy Build. 2000, 31, 97–101. [Google Scholar] [CrossRef]
- Ferrante, A.; Fotopoulou, A.; Semprini, G.; Cantelli, D.; Ruggiero, S.; Karalis, M.; Efthymiou, C.; Papadaki, D.; Assimakopoulos, M.N. IEQ and energy improvement of existing buildings by prefabricated facade additions: The case of a student house in Athens. In Proceedings of the IOP Conference Series: Materials Science and Engineering, Bari, Italy, 5–7 September 2019. [Google Scholar]
- Piasecki, M. Practical Implementation of the Indoor Environmental Quality Model for the Assessment of Nearly Zero Energy Single-Family Building. Buildings 2019, 9, 214. [Google Scholar] [CrossRef]
- Nimlyat, P.S. Indoor environmental quality performance and occupants’ satisfaction [IEQPOS] as assessment criteria for green healthcare building rating. Build. Environ. 2018, 144, 598–610. [Google Scholar] [CrossRef]
- Piasecki, M.; Kostyrko, K.B. Indoor environmental quality assessment, part 2: Model reliability analysis. J. Build. Phys. 2018, 5, 288–315. [Google Scholar] [CrossRef]
- ISO 7726. Ergonomics of the Thermal Environment–Instruments for Measuring Physical Quantities. Available online: https://www.iso.org/standard/14562.html (accessed on 1 November 2020).
- ISO 7730. Ergonomics of the Thermal Environment–Analytical Determination and Interpretation of Thermal Comfort Using Calculation of the PMV and PPD Indices and Local Thermal Comfort Criteria. Available online: https://www.iso.org/standard/39155.html (accessed on 1 November 2020).
- Piasecki, M.; Cisak, M.F.; Biskupski, J.; Furtak, M. Experimental confirmation of the reliability of Fanger’s thermal comfort model—Case study of a near-zero energy building (NZEB) office building. Sustainability 2019, 11, 2461. [Google Scholar] [CrossRef]
- Frontczak, M.; Schiavon, S.; Goins, J.; Arens, E.; Zhang, H.; Wargocki, P. Quantitative relationships between occupant satisfaction and satisfaction aspects of indoor environmental quality and building design. Indoor Air 2012, 22, 119–131. [Google Scholar] [CrossRef]
- Piasecki, M.; Kozicki, M.; Firląg, S.; Goljan, A.; Kostyrko, K. The approach of including TVOCs concentration in the indoor environmental quality model (IEQ)—Case studies of BREEAM certified office buildings. Sustainability 2018, 10, 3902. [Google Scholar] [CrossRef]
- Piasecki, M.; Kostyrko, K.B. Combined Model for IAQ Assessment: Part 1—Morphology of the Model and Selection of Substantial Air Quality Impact Sub-Models. Appl. Sci. 2019, 9, 3918. [Google Scholar] [CrossRef]
- PN-89 Z-04111/03, Ochrona Czystości Powietrza. Badania Mikrobiologiczne. Oznaczanie Liczby Grzybów Mikroskopowych w Powietrzu Atmosferycznym (Imisja) Przy Pobieraniu Próbek Metodą Aspiracyjną i Sedymentacyjną; Polish Standards PKN: Warsaw, Poland, 1989. (In Polish)
- American Conference of Governmental Industrial Hygienists. Threshold Limit Values (Tlvs) for Chemical Substances and Physical Agents and Biological Exposure Indices; ACGIH: Cincinnati, OH, USA, 2001; ISBN 1882417402. [Google Scholar]
- American Industrial Hygiene Association. Biosafety Reference Manual, 2nd ed.; AIHA: Washington, DC, USA, 1986; ISBN 978-0-932627-65-0. [Google Scholar]
- Rao, C.Y.; Burge, H.A.; Chang, J.C.S. Review of Quantitative Standards and Guidelines for Fungi in Indoor Air. J. Air Waste Manag. Assoc. 1996, 46, 899–908. [Google Scholar] [CrossRef]
- Rafferty, P.J. (Ed.) American Industrial Hygiene Association Technical Committee on Indoor Environmental Quality the Industrial Hygienist’s Guide to Indoor Air Quality Investigations; AIHA: Fairfax, VA, USA, 1996; pp. 31–32. [Google Scholar]
- Wanner, H.; Verhoeff, A. Report No. 12: Biological Particles in Indoor Environments; Commission of the European Communities: Luxembourg, 1994. [Google Scholar]
- Bowser Technical Inc. Testing of Older Houses for Microbiological Pollutants; Canada Mortgage and Housing Corporation: Ottawa, ON, Canada, 1991. [Google Scholar]
- Etkin, D.S. Indoor Air Quality Update: Biocontaminants in Indoor Environments; Cutter Information Corp.: Arlington, MA, USA, 1994. [Google Scholar]
- Binnie, P.W.H. Chapter 3: Biological pollutants in the indoor environment. In Indoor Air Pollution; Kay, J.G., Keller, G.E., Miller, J.F., Eds.; Lewis Publishers: Chelsea, MI, USA, 1990. [Google Scholar]
- Indoor Air Quality Association, Inc. Indoor Air Quality Standard #95-1 Recommended for Florida; Indoor Air Quality Association, Inc.: Longwood, FL, USA, 1995. [Google Scholar]
- Malmberg, P. Microorganisms. In Criteria Documents from the Expert Group; Beije, B., Lundberg, P., Eds.; Arbets Milio Institutet: Solna, Sweden, 1991; pp. 39–69. [Google Scholar]
- Heida, H.; Bartman, E.; van der Zee, S.C. Occupational exposure and indoor air quality monitoring in a composting facility. AIHAJ 1995, 56, 39–43. [Google Scholar] [CrossRef]
- New York City Department of Health. Guidelines on Assessment and Remediation of Stachybotrys atra in Indoor Environments. In Proceedings of the International Conference, Saratoga Springs, NY, USA, 6–7 October 1994. [Google Scholar]
- United States Occupational Safety and Health Administration. Indoor Air Quality-Proposed Rule. Notice of Proposed Rulemaking; U.S. Government Publishing Office: Washington, DC, USA, 1994; Volume 59, pp. 15968–16039. [Google Scholar]
- World Health Organization WHO Regional Publications European Series, No. 31: Indoor Air Quality: Biological Contaminants; Report on a WHO Meeting; WHO: Copenhagen, Denmark, 1988.
- Dehaene, S. The neural basis of the Weber-Fechner law: A logarithmic mental number line. Trends Cogn. Sci. 2003, 7, 145–147. [Google Scholar] [CrossRef]
- Piasecki, M.; Kostyrko, K. Development of Weighting Scheme for Indoor Air Quality Model Using a Multi-Attribute Decision Making Method. Energies 2020, 13, 3120. [Google Scholar] [CrossRef]
- AS/NZS 2107:2000. Acoustics—Recommended Design Sound Levels and Reverberation Times for Building Interiors; Australian Standards: Sydney, Australia, 2000. [Google Scholar]
- Hunt DRG. Predicting artificial lighting use—A method based upon observed patterns of behaviour. Lighting Res. Technol. 1980, 12, 7–14. [Google Scholar] [CrossRef]
- PN-B-02151-2:2018-01 Akustyka Budowlana–Ochrona Przed Hałasem w Budynkach–Część 2: Wymagania Dotyczące Dopuszczalnego Poziomu Dźwięku w Pomieszczeniach; Polish Standards PKN: Warsaw, Poland, 2018. (In Polish)
- PN EN 12464-1:2012 Light and Lighting-Lighting of Work Places-Part 1: Indoor work. The European Committee for Standardization CEN. Available online: https://sklep.pkn.pl/pn-en-12464-1-2012p.html (accessed on 1 November 2020).
- Watanabe, T. Pictorial Atlas of Soil and Seed Fungi: Morphologies of Cultured Fungi and Key to Species, 3rd ed.; CRC Press: Cleveland, OH, USA, 2010. [Google Scholar]
- Kozicki, M.; Wiejak, A.; Piasecki, M.; Abram, A. Identification of MVOCs Produced by Coniophora puteana and Poria placenta Growing on WPC Boards by Using Subtraction Mass Spectra. Int. J. Environ. Res. Public Health 2019, 16, 2499. [Google Scholar] [CrossRef] [PubMed]
- Mancini, F.; Nastasi, B. Energy Retrofitting Effects on the Energy Flexibility of Dwellings. Energies 2019, 12, 2788. [Google Scholar] [CrossRef]
- Ortiz, M.; Itard, L.; Bluyssen, P.M. Indoor environmental quality related risk factors with energy-efficient retrofitting of housing: A literature review. Energy Build. 2020, 221, 110102. [Google Scholar] [CrossRef]
- Steidl, T.; Krause, P. Moisture transport in cellular concrete walls with the connector for thermal insulation. Period. Polytech. Civ. Eng. 2018, 62, 986–991. [Google Scholar]
- Kisilewicz, T. On the role of external walls in the reduction of energy demand and the mitigation of human thermal discomfort. Sustainability 2019, 11, 1061. [Google Scholar] [CrossRef]
- Krause, P.; Nowoświat, A.; Pawłowski, K. The Impact of Internal Insulation on Heat Transport through the Wall: Case Study. Appl. Sci. 2020, 10, 7484. [Google Scholar] [CrossRef]
- Firląg, S.; Piasecki, M. NZEB Renovation Definition in a Heating Dominated Climate: Case Study of Poland. Appl. Sci. 2018, 8, 1605. [Google Scholar] [CrossRef]

| Technical Property | Value |
|---|---|
| Dry density | 220 kg/m3 |
| Porosity | 90% by volume |
| Thermal conductivity coefficient | 0.059 W/m·K |
| Water vapor permeability coefficient | 3 |
| pH | 12 |
| IAQ Impact Level | PD | PN-89 [44] | ACGIH [45] | AIHA [46,47,48] | CEC [49] | CHMC [50] | CIC [51] | HBI [52] | IAQA [53] | NHW [54] | NI [55] | NC [56] | USSHA [57] | WHO [58] |
|---|---|---|---|---|---|---|---|---|---|---|---|---|---|---|
| low | 10% | 100 | 100 | 100 | 150 | 150 | 150 | |||||||
| moderate | 25% | 3000 | 1000 | 1000 | 500 | 200 | 750 | 500 | 500 | 1000 | 500 | |||
| high | 50% | 1000 | ||||||||||||
| very high | 75% | 5000 | ||||||||||||
| health effects | 100% | 10,000 | 10,000 | 10,000 |
| Sensor Type | Range | Scale | Accuracy |
|---|---|---|---|
| Temperature FHAD46 | –20 °C to 50 °C | 0.01 °C | ±0.5 °C |
| Humidity FHAD46 | 0–100% | 0.1% | ±5% |
| Air velocity FVAD15 | 0.01–10 m/s | 0.01 m/s | ±2% |
| Radiant temperature FIAD43 | 0–50 °C | 0.01 °C | ±2% |
| Sensor Type | Range | Scale | Accuracy |
|---|---|---|---|
| VOCs PID detector | 10−20,000 ppb | 1 ppb | ±20% |
| CO2 detector FYAD00 | 0−5000 | 1 ppm | ±0.6% |
| Space | IAQquality | TCindex | ACcindex | Lindex | |||||||
|---|---|---|---|---|---|---|---|---|---|---|---|
| ∆CO2 (ppm) | TVOC (µg/m3) | HCHO (µg/m3) | CFU (CFU/m3) | PMV (–) | va (m/s) | Iclo (clo) | M (met) | LAeq (dB) | LDesign (dB) | Emin (lux) | |
| non-retrofitted (winter) | 251 ± 3 | 550 ± 110 | 7.2 ± 1 | 1330 ± 360 | −1.18 | 0.1 ± 0.05 | 1 | 1.2 | 42 ± 3 | 40 | 225 ± 25 |
| non-retrofitted (summer) | 212 ± 3 | na * | 6.8 ± 1 | na | −1.17 | 0.2 ± 0.05 | 0.7 | 1.1 | na | 40 | 375 ± 25 |
| non-retrofitted averaged | 232 ± 3 | 550 ± 110 | 7.0 ± 1 | 1330 ± 360 | −1.17 | 0.2 ± 0.05 | 0.9 | 1.1 | 42 ± 3 | 40 | 300 ± 25 |
| retrofitted (winter) | 268 ± 3 | 340 ± 70 | 6.2 ± 1 | 53 ± 16 | 0.05 | 0.1 ± 0.05 | 1 | 1.2 | 36 ± 3 | 40 | 225 ± 25 |
| retrofitted (summer) | 281 ± 3 | na | 6.4 ± 1 | na | −0.61 | 0.2 ± 0.05 | 0.7 | 1.1 | na | 40 | 350 ± 25 |
| retrofitted averaged | 275 ± 3 | 340 ± 70 | 6.3 ± 1 | 53 ± 16 | −0.26 | 0.2 ± 0.05 | 0.9 | 1.1 | 36 ± 3 | 40 | 287 ± 25 |
| IAQCO2 | IAQTVOC | IAQHCHO | IAQCFU | ΣIAQinde | TCindex | Accindex | Lindex | IEQindex | |
|---|---|---|---|---|---|---|---|---|---|
| Space | (%) | (%) | (%) | (%) | (%) | (%) | (%) | (%) | (%) |
| non-retrofitted (winter) | 92 ± 1 | 71 ± 18 | 94 ± 11 | 52 ± 27 | 57 ± 19 | 67 ± 3 | 96 ± 7 | 91 ± 7 | 78 ± 20 |
| non-retrofitted (summer) | 93 ± 1 | na * | 94 ± 11 | na | na | 67 ± 3 | na | 97 ± 7 | 80 ± 20 |
| non-retrofitted average | 92 ± 1 | 71 ± 18 | 94 ± 11 | 52 ± 27 | 57 ± 19 | 67 ± 3 | 96 ± 7 | 95 ± 7 | 79 ± 20 |
| retrofitted (winter) | 91 ± 1 | 61 ± 18 | 94 ± 11 | 100 ± 27 | 92 ± 19 | 95 ± 3 | 100 ± 7 | 91 ± 7 | 94 ± 20 |
| Retrofitted (summer) | 91 ± 1 | na | 94 ± 11 | na | na | 87 ± 3 | na | 97 ± 7 | 93 ± 20 |
| retrofitted average | 91 ± 1 | 61 ± 18 | 94 ± 11 | 100 ± 27 | 92 ± 19 | 91 ± 3 | 100 ± 7 | 95 ± 7 | 94 ± 20 |
| Medium | SPACE (CFU/m3) | ||||||
|---|---|---|---|---|---|---|---|
| Energy-Retrofitted Cellar FEEE * | Non-Retrofitted Spaces FEEE * | Non-Retrofitted Cellar FA * | |||||
| 1 | 2 | 3 | 4 | 1 | 2 | 3 | |
| RBA | 5 | 95 | 100 | 2 | 1880 | 845 | 370 |
| SGA | 25 | 75 | 85 | 30 | 1560 | 1105 | 710 |
| Fungi | Room | |||||||||||
|---|---|---|---|---|---|---|---|---|---|---|---|---|
| Energy-Retrofitted Cellar FEEE | Non-Retrofitted Cellar FA | Non-Retrofitted Spaces FEEE | ||||||||||
| 1 | 2 | 3 | 1 | 2 | 3 | |||||||
| RBA | SGA | RBA | SGA | RBA | SGA | RBA | SGA | RBA | SGA | RBA | SGA | |
| Aspergillus sp. | - | - | - | - | - | - | - | - | - | - | - | - |
| Aspergillus niger | - | + | - | - | - | - | - | - | - | - | - | - |
| Aspergillus versicolor | - | - | - | - | - | - | + | - | ++ | ++ | - | - |
| Aspergillus ochraceus | - | - | - | - | - | - | - | - | - | ++ | - | - |
| Penicillium sp. | - | - | + | + | - | - | - | - | ++ | ++ | - | - |
| Chaetomium sp. | - | - | - | - | - | - | - | - | ++ | ++ | - | - |
| Paecilomyces variotti | + | - | - | - | - | - | - | - | - | - | - | - |
| Trichoderma sp. | + | + | - | - | - | - | - | - | - | - | - | - |
| Measurement | 1 | 2 | 3 | 4 | 5 | Average Value |
|---|---|---|---|---|---|---|
| RH (%) | 36.4 | 36.2 | 36.2 | 36.1 | 36.1 | 36.2 |
| VOCs (ppb) | 120 | 160 | 140 | 200 | 110 | 146 |
| VOCs (µg/m3) * | 280 | 370 | 320 | 460 | 250 | 340 |
| Measurement | 1 | 2 | 3 | 4 | 5 | Average Value |
|---|---|---|---|---|---|---|
| RH (%) | 42.4 | 42.6 | 42.2 | 42.7 | 42.4 | 42.5 |
| VOCs (ppb) | 260 | 240 | 210 | 240 | 240 | 238 |
| VOCs (µg/m3) | 600 | 550 | 480 | 550 | 550 | 550 |
| Measurement | 1 | 2 | 3 | 4 | 5 | Average Value |
|---|---|---|---|---|---|---|
| RH (%) | 40.4 | 40.6 | 40.2 | 40.7 | 40.4 | 40.5 |
| VOCs (ppb) | 160 | 140 | 210 | 180 | 160 | 170 |
| VOCs (µg/m3) | 370 | 320 | 480 | 410 | 370 | 390 |
| ∆ΣIAQindex | ∆TCindex | ∆Accindex | ∆Lindex | ∆IEQindex | |
|---|---|---|---|---|---|
| Method | (%) | (%) | (%) | (%) | (%) |
| IEQ (measurement + sensory curves) | +35% | +24% | +4% | 0% | +15% |
| Survey (vote) | +38% | +33% | +13% | 0% | +23% |
Publisher’s Note: MDPI stays neutral with regard to jurisdictional claims in published maps and institutional affiliations. |
© 2020 by the authors. Licensee MDPI, Basel, Switzerland. This article is an open access article distributed under the terms and conditions of the Creative Commons Attribution (CC BY) license (http://creativecommons.org/licenses/by/4.0/).
Share and Cite
Piasecki, M.; Radziszewska-Zielina, E.; Czerski, P.; Fedorczak-Cisak, M.; Zielina, M.; Krzyściak, P.; Kwaśniewska-Sip, P.; Grześkowiak, W. Implementation of the Indoor Environmental Quality (IEQ) Model for the Assessment of a Retrofitted Historical Masonry Building. Energies 2020, 13, 6051. https://doi.org/10.3390/en13226051
Piasecki M, Radziszewska-Zielina E, Czerski P, Fedorczak-Cisak M, Zielina M, Krzyściak P, Kwaśniewska-Sip P, Grześkowiak W. Implementation of the Indoor Environmental Quality (IEQ) Model for the Assessment of a Retrofitted Historical Masonry Building. Energies. 2020; 13(22):6051. https://doi.org/10.3390/en13226051
Chicago/Turabian StylePiasecki, Michał, Elżbieta Radziszewska-Zielina, Piotr Czerski, Małgorzata Fedorczak-Cisak, Michał Zielina, Paweł Krzyściak, Patrycja Kwaśniewska-Sip, and Wojciech Grześkowiak. 2020. "Implementation of the Indoor Environmental Quality (IEQ) Model for the Assessment of a Retrofitted Historical Masonry Building" Energies 13, no. 22: 6051. https://doi.org/10.3390/en13226051
APA StylePiasecki, M., Radziszewska-Zielina, E., Czerski, P., Fedorczak-Cisak, M., Zielina, M., Krzyściak, P., Kwaśniewska-Sip, P., & Grześkowiak, W. (2020). Implementation of the Indoor Environmental Quality (IEQ) Model for the Assessment of a Retrofitted Historical Masonry Building. Energies, 13(22), 6051. https://doi.org/10.3390/en13226051

